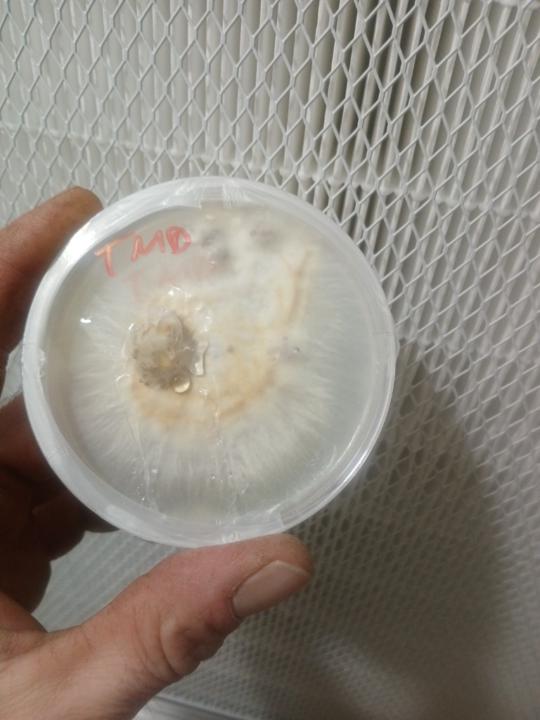
Tyler Allen

Activity
Mon
Wed
Fri
Sun
Jul
Aug
Sep
Oct
Nov
Dec
Jan
Feb
Mar
Apr
May
What is this?
Less
More
Memberships
Southwest Mushrooms
151 members • $59/month
Contributions

@tyler-allen-1097
Mushroom Manager
Active 151d ago
Joined Dec 20, 2025
Powered by
151 members • $59/month